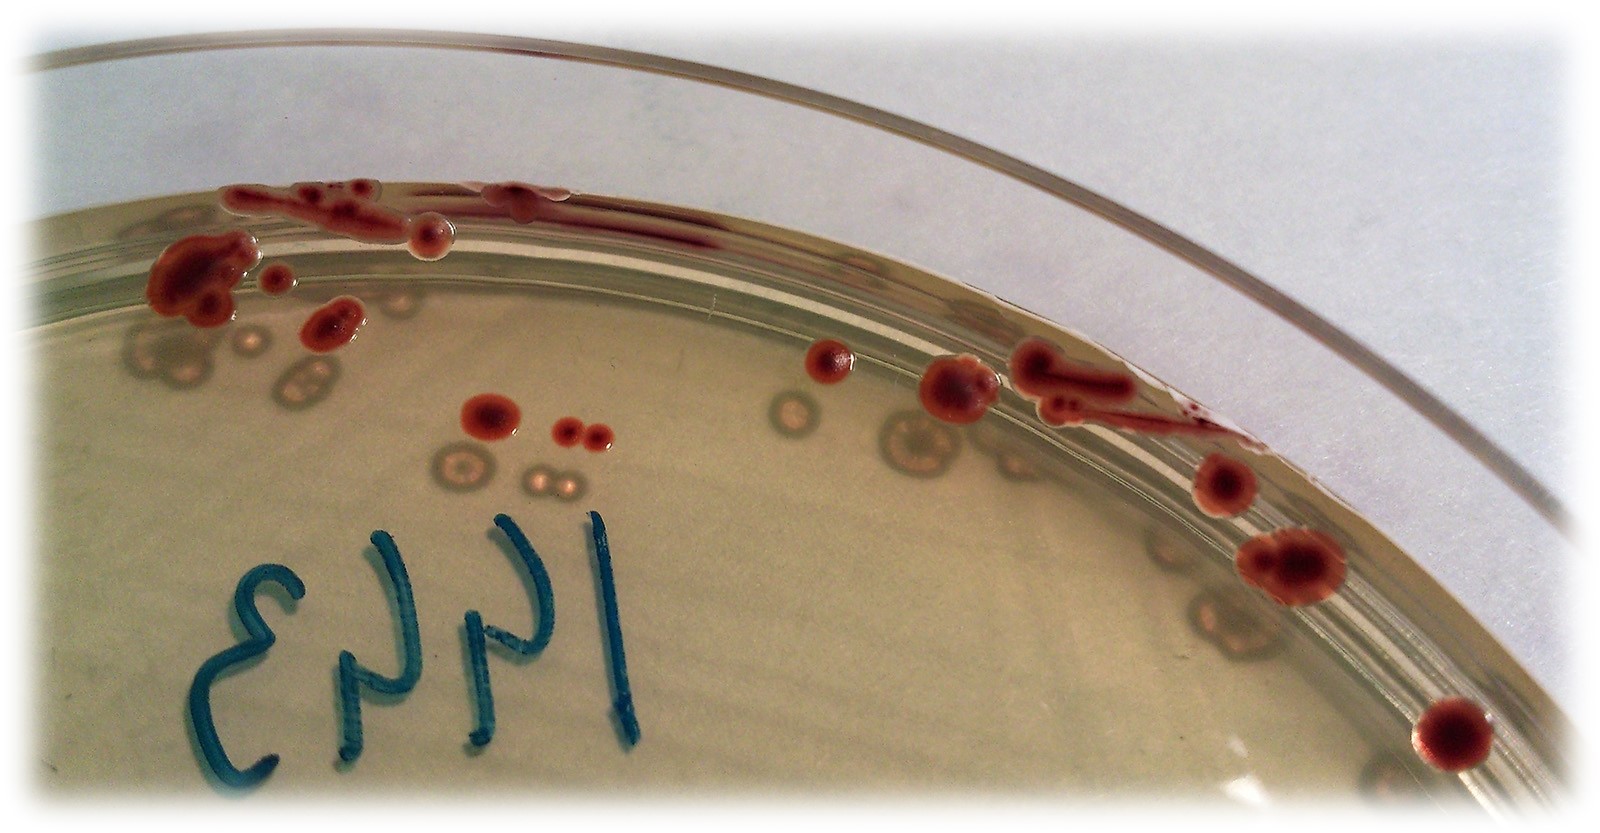

METAVICS (Terminé)
Le projet
Campylobacter et Salmonella sont responsables des deux zoonoses bactériennes d’origine alimentaires majoritaires en Europe. La viande de volaille a été identifiée comme source de contamination humaine dans la majorité des salmonelloses et campylobacterioses : en France, 76,1% des élevages de poulet de chair et 88,7 % des carcasses sont contaminées par Campylobacter et 7,6 % des carcasses le sont par Salmonella, les deux pathogènes pourraient donc être présents simultanément dans le tube digestif des animaux. Sur la base de ces résultats, il est nécessaire d'entamer la recherche seule et simultanée de ces deux pathogènes afin d’étudier l’impact des mesures de gestion prises pour l’un sur l’autre
Du point de vue du microbiome, des études préliminaires ont montré que Salmonella enterica sérotype Typhimurium et Campylobacter jejuni influaient sur le microbiote gastro-intestinal des poulets de chair
Du point de vue du métabolome, il a été démontré que le microbiote fécal avait la faculté d’impacter les métabolites de l’hôte. La comparaison d'empreinte chimique a d'ailleurs mis en évidence des différences significatives entre le métabolome sérique de porcs infectés et non infectés par la salmonelle mais aussi entre les animaux fortement et faiblement excréteurs. Des résultats similaires pourraient être attendus chez le poulet dans le cadre de ce projet
L'apport de résultats permettrait de contribuer à l’apport de nouvelles connaissances sur l’effet de la contamination animale en étudiant le lien avec les modifications du microbiote caecal. De nouveaux résultats permettrait également de mettre en évidence des biomarqueurs au niveau du métabolome sérique spécifiquement associés aux contaminations par Campylobacter et Salmonella
Les objectifs de ce projet sont les suivants :
1. Etudier la colonisation du poulet de chair contaminé par Campylobacter et/ou Salmonella
2. Etudier le microbiote intestinal du poulet de chair contaminé par Campylobacter et/ou Salmonella
3. Etudier la variation métabolomique chez le poulet de chair contaminé par Campylobacter et/ou Salmonella
4. Analyser les données associant la colonisation avec les variations métagénomiques du microbiote intestinal et du métabolome du poulet de chair
5. Intégrer les données dans des modèles d’appréciation des risques